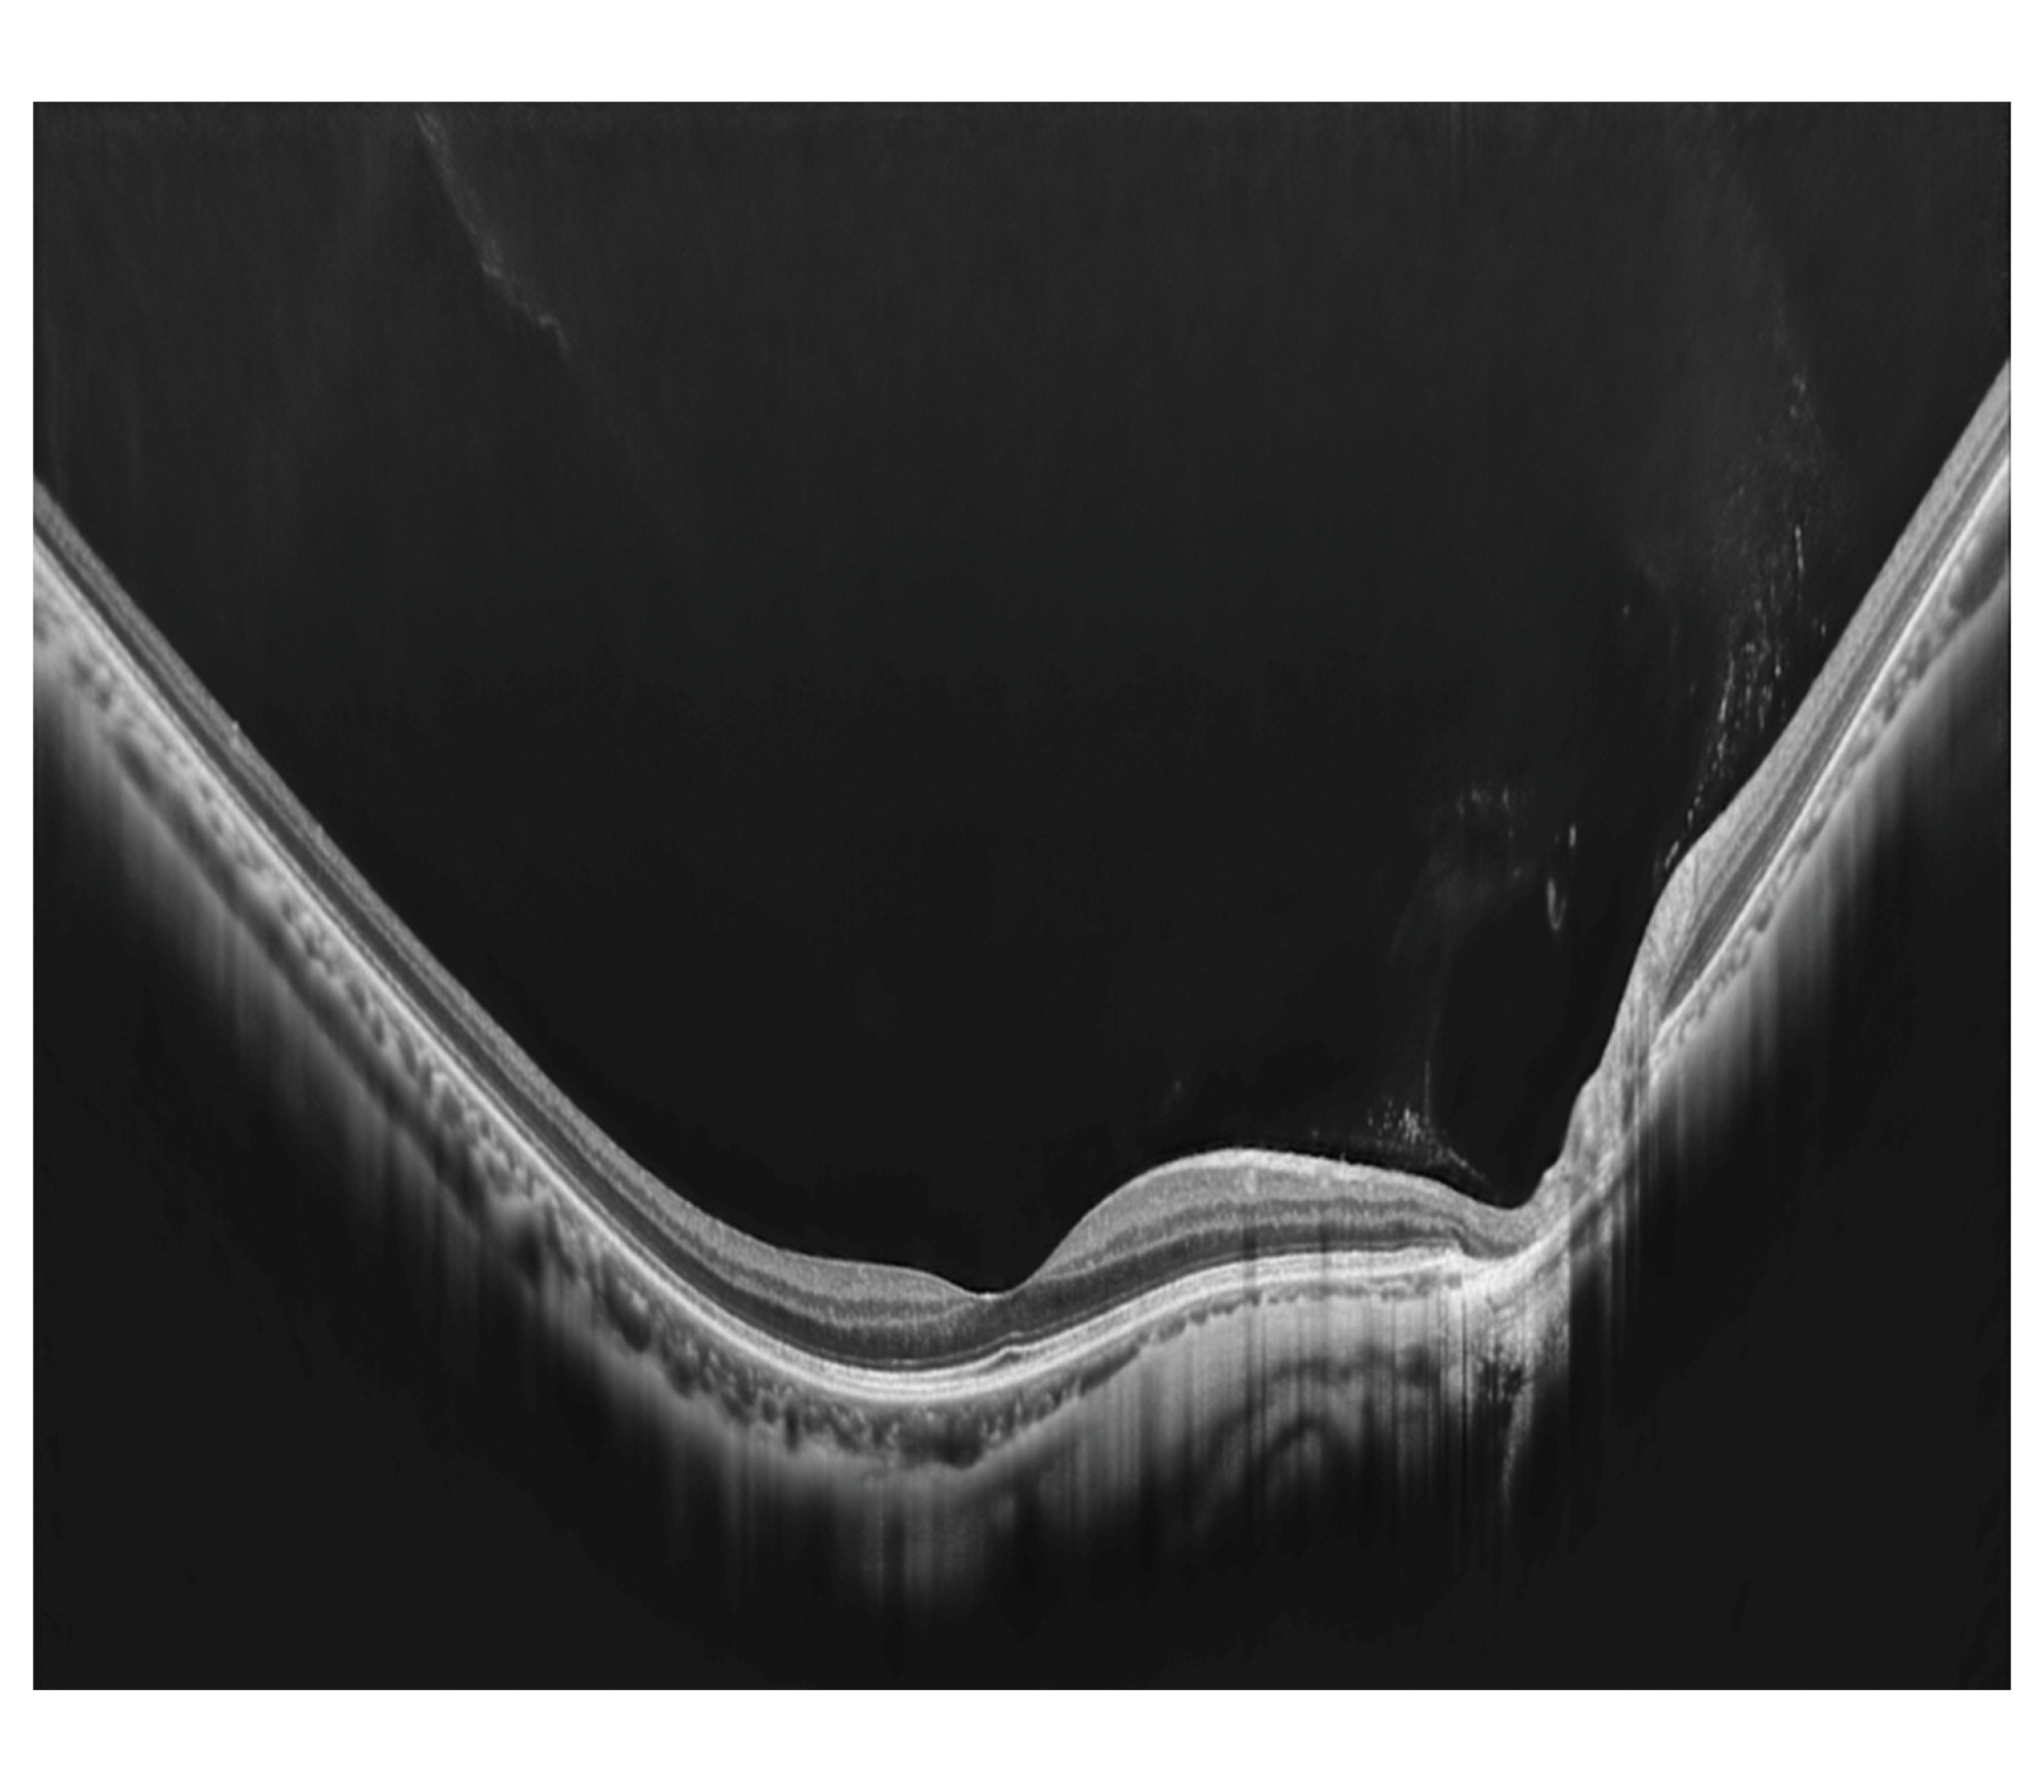

光干渉断層計
Glauvas
ここから先のページは、日本国内の医療関係者を対象として当社の医療向け製品情報を提供しております。
国外の医療関係者、および一般の方に対する情報提供を目的としたものではありませんので、対象外の方は閲覧をご遠慮ください。
光干渉断層計
Glauvas

“狙った位置を撮る”から“必要な画像を選ぶ”へ
特長
- 250,000 A-scans/s 高速撮影
- Glauvas 網膜マップ 15×12mm 水平B-scan+GCC+RNFL
- Rapid track scan(3Dマップ高速トラッキング撮影)
- 前眼部3Dオートアライメント機構
機能・性能
250,000 A-scans/s 高速撮影
高速ラインセンサーを搭載し、膨大な情報を短い時間で取得することが可能です。
マップ撮影後の各B-scan画像は、加算撮影同等の画像が任意の場所で表示できます。
![]() |
![]() |
|
| ※Bスキャンデノイジングソフトウェア(オプション)使用時 |
Glauvas 網膜マップ 15×12mm 水平B-scan+GCC+RNFL
ひとつの検査結果でさまざまな網膜疾患の診断に必要な画像や解析結果を表示することができます。
※Glauvasとは、GlaucomaとVascularを語源とした造語です
![]() |
![]() |
4.2mm Deep scan
従来機種*1 の2.1mmよりも深いエリアの信号をとらえることができるため、湾曲の強い眼底の撮影が容易となります。
*1 共焦点走査型ダイオードレーザ検眼鏡 Mirante、光干渉断層計 RS-3000 Advance
![]() |
Rapid track scan (3Dマップ高速トラッキング撮影)
| 3Dマップ撮影時の「トラッキング撮影」を高速化しました。 | ![]() |
| 眼底の高速トラッキングは、まばたきや固視不良の影響も 低減することができ、撮影位置を調整し精度の高い 3Dスキャンが可能となります。 |
![]() |
前眼部3Dオートアライメント機構
角膜輝点を検知するオートトラッキング機能を採用し、安定した撮影位置の追従を実現しました。
ジョイスティックを使わずマウスで簡単にアライメント操作が可能です。
![]() |
![]() |
Glauvas網膜マップ 緑内障 両眼解析表示
ひとつの検査結果で緑内障の診断に必要なさまざまな解析結果を表示することができます。
![]() |
![]() |
![]() |
OCT解析用スキャン幅補正パラメーター ※オプション
黄斑ライン撮影で得た眼軸長*4をもとにスキャン幅補正を自動でおこなうことが可能です。
*4 OCT画像の取り込み結果に基づいて求められ、実測値とは異なります
![]() |
![]() |
![]() |
長眼軸長正常眼データベース ※オプション
26mm以上29mm未満の眼軸長に対応した正常眼データベースです。
![]() |
|
![]() |
Bスキャンデノイジングソフトウェア ※オプション
ディープラーニング*5 用いたアルゴリズムでB-scan画像のノイズを除去することが可能です。
![]() |
*5 設計段階でのみ用いており、製品での自律学習はいたしません
ディープラーニング セグメンテーション
ディープラーニング*5 を用いたアルゴリズムで網膜層の形態に応じたセグメンテーションが可能です。
![]() |
*5 設計段階でのみ用いており、製品での自律学習はいたしません
SN マップ(Structural normality map)
正常とは異なる網膜構造を層ごとに確認することができます。
![]() |
OCT-Angiography ※オプション
6/9/12 mmの撮影に対応し、広範囲でも微細な血流信号を描出できます。
![]() |
仕様
- 販売名
- 光干渉断層計 RS-1
- 機器分類
- 管理医療機器/特定保守管理医療機器
- 認証番号
- 305AABZX00045000
- 希望小売価格
- ー
資料ダウンロード
ニデックWeb会員様限定コンテンツです。